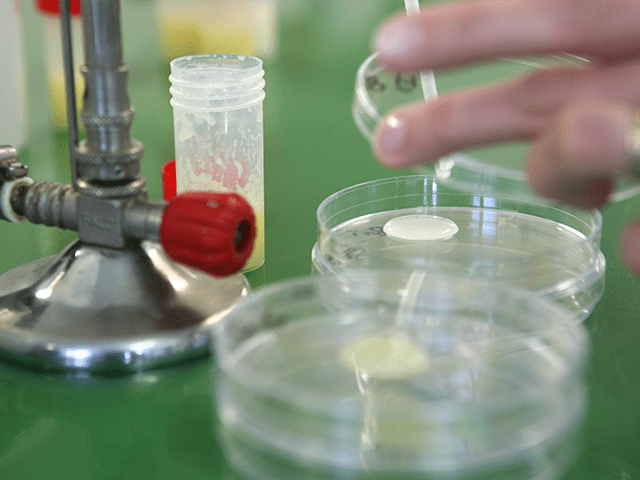

Du champ à l’assiette – EPISODE 3 : Le contrôle qualité des produits
Au travers des deux épisodes précédents, nous vous avons dévoilé les étapes de la collecte du lait et celles de la fabrication de nos produits. Ce processus est sous surveillance constante : par les opérateurs, mais aussi et surtout par le service Qualité. Françoise COL, responsable du service, et son équipe s’assurent de la bonne conformité des produits et de la bonne mise en œuvre des contrôles. Découvrez comment.
Le contrôle de la qualité : la dernière étape avant de libérer le produit
Les normes et labels, gages de qualité de nos produits
La Laiterie du Forez, entreprise agro-alimentaire, est engagée dans la démarche de la norme internationale ISO 22000. Elle s’appuie de même sur le système HACCP pour la gestion des risques (Hazard Analysis Critical Contrôle Point).
La norme ISO 22000 permet d’établir un système de management de la sécurité et de la qualité qui permet au fabricant d’identifier les risques et de les maîtriser. Pour vous, consommateur, c’est un gage de sécurité des aliments que vous consommez et un gage de confiance et de professionnalisme que vous donne l’entreprise.
Le système HACCP est une méthode de travail plus qu’une norme. Ce système permet d’identifier les points critiques pour mieux les maîtriser.
Par ailleurs, certains produits sont labellisés et répondent à des cahiers des charges précis :
- La gamme Bio de Lait du Forez répond au exigences du Label AB – Agriculture Biologique,
- Les faisselles moulées à la louche sont les seules faisselles françaises labellisées Label Rouge.
Ces labels sont d’autant plus de gages de notre engagement à vous offrir les meilleurs produits sur le marché.
Les procédures de contrôle qualité au sein de la Laiterie du Forez
De l’entrée du lait dans les cuves de la Laiterie du Forez à la sortie du produit fini en camion vers les points de vente, les protocoles de contrôles et de suivis sont omniprésents et rigoureux.
3 étapes de tests sont identifiables :
- Contrôles physico-chimiques automatiques des matières premières (lait et autres composants dès leur arrivée à la Laiterie). Tous les produits sont par ailleurs traités thermiquement (pour éviter les germes) ;
- A chaque étape de production, un contrôle est effectué selon un protocole précis par les opérateurs et des relevés d’échantillons sont remontés au laboratoire pour tests ;
- Le contrôle final est celui qui permet ou non la libération du produit. Sur des échantillons récoltés sur chaque lot de production, une série de tests microbiologiques en laboratoire sont réalisés. Si les résultats sont conformes à la tolérance du protocole, alors le produit est libéré. Dans le cas contraire, le lot est retiré, détruit ou pasteurisé à nouveau dans certains cas. Aucun produit ne sort de la Laiterie du Forez sans avoir le résultat favorable des tests finaux.

Une procédure rigoureuse qui assure la traçabilité du produit
Chaque résultat de test/contrôle du cycle de production est rigoureusement enregistré et conservé 5 ans.
Grâce à un protocole précis, la traçabilité de chaque produit est assurée. Chaque produit à son numéro de lot, sa DLC (Date de Limite de Conservation après laquelle on ne peut garantir le maintien de la qualité du produit).
Dès qu’un problème est mis en lumière, le service qualité s’engage dans une enquête pour en trouver l’origine du problème et le résoudre.
Le service Qualité détient toutes les cartes pour vous assurer la conformité du produit jusque dans votre assiette. A la fois à l’origine des protocoles sanitaires, il est aussi l’exécutant principal et le garant de la bonne mise en œuvre par tous les opérateurs à chaque étape de production.
La Laiterie du Forez met tout en œuvre pour vous certifier la qualité de ses produits. Alors régalez-vous !


